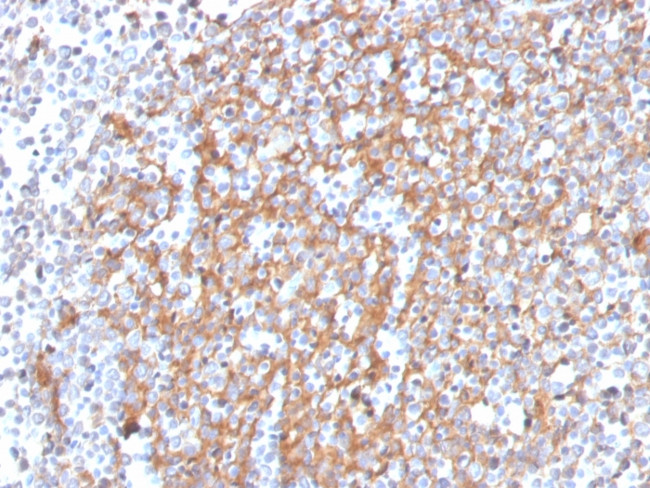
Cystatin A Antibody in Immunohistochemistry (Paraffin) (IHC (P))

Search
NeoBiotechnologies
Cystatin A Monoclonal Antibody (CSTA, 3553)
{{$productOrderCtrl.translations['antibody.pdp.commerceCard.promotion.promotions']}}
{{$productOrderCtrl.translations['antibody.pdp.commerceCard.promotion.viewpromo']}}
{{$productOrderCtrl.translations['antibody.pdp.commerceCard.promotion.promocode']}}: {{promo.promoCode}} {{promo.promoTitle}} {{promo.promoDescription}}. {{$productOrderCtrl.translations['antibody.pdp.commerceCard.promotion.learnmore']}}
产品信息
1475-MSM3-P1ABX
种属反应
宿主/亚型
分类
类型
克隆号
抗原
偶联物
形式
浓度
规格
纯化类型
保存液
内含物
保存条件
运输条件
产品详细信息
Immunohistochemistry (PFA fixed): incubate antibody for 30 min RT. Staining of formalin-fixed tissues requires heating tissue sections in 10mM Tris with 1mM EDTA, pH 9.0, for 45 min at 95 degrees C followed by cooling at RT for 20 minutes.
靶标信息
The cystatin superfamily encompasses proteins that contain multiple cystatin-like sequences. Some of the members are active cysteine protease inhibitors, while others have lost or perhaps never acquired this inhibitory activity. There are three inhibitory families in the superfamily, including the type 1 cystatins (stefins), type 2 cystatins, and kininogens. This gene encodes a stefin that functions as a cysteine protease inhibitor, forming tight complexes with papain and the cathepsins B, H, and L. The protein is one of the precursor proteins of cornified cell envelope in keratinocytes and plays a role in epidermal development and maintenance. Stefins have been proposed as prognostic and diagnostic tools for cancer.
仅用于科研。不用于诊断过程。未经明确授权不得转售。
篇参考文献 (0)
生物信息学
蛋白别名: CSTA; cystatin A (stefin A); cystatin AS; Cystatin-A; Cystatin-AS; Stefin A; Stefin-A; unnamed protein product
基因别名: AREI; CSTA; PSS4; STF1; STFA
UniProt ID: (Human) P01040
Entrez Gene ID: (Human) 1475